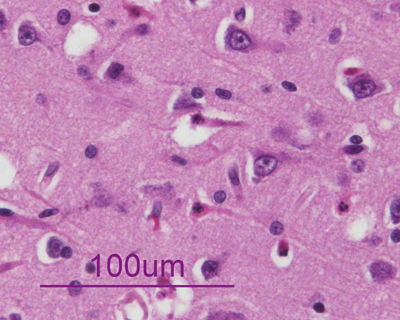

Developmental Neuropathology
Chapter 20: White matter lesions in the perinatal period
Periventricular Leukomalacia
Periventricular leukomalacia (PVL) is a lesion of immature cerebral white matter in the perinatal period. Two components:
1. "focal" necrotic periventricular region
2. "diffuse" reactive gliosis of the surrounding white matter
Each area has different longterm results:
Focal necrosis --> cysts that may collapse into focal scars
Diffuse gliosis --> loss of premyelinating oligodendrocytes --> global delayed myelination
Clinical significance suggested:
Focal necrosis --> cerebral palsy, motor deficit
Diffuse gliosis --> cognitive and behavioural abnormalities
First described by Virchow in the mid 19th century, and also by Parrot around that time. Later, detailed neuropathological descriptions were made by Banker and Larroche in 1962. The cystic nature of PVL is a severe end of the spectrum, and as described by Volpe, is no longer as commonly seen in PVL in recent years. The incidence of CP, however, has not decreased.
Epidemiology
- 55,000 births in US annually <1500g, with 90% survival
- 10% develop cerebral palsy, 50% develop cognitive and behavioural deficits
- PVL is most important factor in these deficits
- Periventricular cysts on HUS in the neonatal period may underestimate the incidence of PVL
- PVL diagnosed by HUS: 8% in infants <36 wks GA, highest incidence at 28wks (16%)
- Highest risk of PVL between 24-35 wks, but can occur up to 2 months postnatally
Risk factors
- Gestational age at birth - most important factor
- Intrauterine infection
- materinal UTI
- other maternal infections
- maternal fever
- proven sepsis in infant at delivery
- chorioamnionitis
- premature ROM - with intrauterine infection at 24-32 wks GA = 22% risk of PVL
- prolonged ROM
- cardiopulmonary instability in mother/fetus
- first trimester hemorrhage
- neonatal acidosis at birth (pH <7.2)
- meconium-stained amniotic fluid
- RDS
- low Apgar scores
- persistent apneic episodes
- inotropic support
- PDA
- prolonged ventilatory/oxygen support
- effect of abnormal cerebrovascular autoregulation in hypotension, unstable fetal heart rate patterns, including variable decelerations
- tocolysis to prolong a pregnancy >24 hours
- minimal risks also from IUGR, preeclampsia, rapid/unexpected delivery
- risk factors vary at different birth weights, e.g., hypocarbia affects 1000-1500g babies more than <1000g or >1500g babies
- PVL seen in stillborns associated with chronic placental vascular changes, umbilical cord problems, old infarction/abruption, placental meconium staining (suggesting intrauterine hypoxia-ischemia)
Genetics
- some polymorphisms may be at greater risk for PVL
- e.g. factor XIII 34Leu polymorphisms decreases white matter disorders
- factor XIII cross-links fibrin to stabilize clots
- polymorphism accelerates activation by fibrin and increases risk of primary intracerebral hemorrhage while decreasing risk of brain infarction in adults
- e.g. allelic variation in the Toll-like receptor-4 associated with increased risk for prematurity and gram negative sepsis
Clinical features
- since PVL occurs in sick premature infants with multiple medical problems, hard to tease out specific symptoms
- can show weakness in lower limbs in the first few weeks of life
- more apneas and neonatal seizures
- up to 70% have benign clinical course
- diagnostic studies are head ultrasound and MRI
- HUS is of limited value at detecting PVL - sensitivity 50%, specificity 87%
- even in absence of cysts, MRI can detect diffuse white matter abnormality and ventriculomegaly
- longterm risks:
- cerebral palsy, mental retardation, learning deficits, seizures
- parieto-occipital cysts associated with cerebral palsy (disruption of corticospinal tracts), but anterior cysts can be asymptomatic
- PVL is seen in 25% SIDS cases
- longterm radiological findings are resolution of periventricular cysts, ventriculomegaly, reduced periventricular white matter volume, and delayed myelination
Macroscopy
- necrotic foci usually within 15mm of ventricular wall, 2-6 mm in diameter
- common locations:
- anterior to frontal horn
- lateral corners of the lateral ventricles at level of foramen of Monroe
- lateral regions of the trigone and occipital horn (including optic radiations)
- acute foci of coagulation necrosis not visible in gross
- organized foci seen as "White spots" due to lipid-laden macrophages
- cavitation follows, then collapse into a glial scar (or remains cystic if severe)

- long-standing damage shows thinned white matter and corpus callosum, and ventriculomegaly
Histopathology
- coagulation necrosis within 24 hours of insult
- dissolution of all cell types
- hypereosinophilia
- nuclear pyknosis


- acutely necrotic, swollen axons (spheroids) - confirmed with human beta-amyloid precursor protein immunostaining



- within a week
- organization of necrosis with infiltrating macrophages
- reactive astrocytes in the margin
- in a few weeks
- cavitation into periventricular cysts
- collapse of cysts into glial scars with lipid-laden macrophages and mineralized axons
- gliosis preferentially in deep white matter compared to intragyral white matter

- PVL usually coexists with other perinatal pathologies including grey matter lesions
- longterm consequence of delayed myelination
- from loss of developing oligodendrocytes
- or from deprivation of afferent terminals from underlying white matter lesion
Immunohistochemistry
- research-oriented tests
- CD68 - activated microglia in the necrotic lesions
- products of nitrosative and oxidative stress - antibodies to 4-hydroxy-2-nonenal protein adducts (HNE) and nitrotyrosine protein adducts (NT) - in premyelinating oligodendrocytes in the diffuse component
- TUNEL staining to detect developing oligodendrocyte cell death
- role of cytokines (IFN-gamma, TNF-alpha, ILs) in the inflammatory component (reactive astrocytes and macrophages)
- myelin transcription factor 1 (MyT1) increased around necrotic foci, normally expressed in oligodendrocyte progenitors - myelin repair around necrotic foci
Differential Diagnosis
- primary differentials include
- diffuse cerebral white matter gliosis - no accompanying white matter necrosis
- venous infarction - usually in picture of massive hemorrhage
Pathogenesis
- PVL likely targets primarily premyelinating oligodendrocytes
- PVL occurs mainly between 24-32 wks GA - before myelination (MBP+ oligodendrocytes)
- longterm consequence of diffuse delayed myelination
- current research underway to understand the sensitivity of premyelinating oligodendrocytes to hypoxia-ischemia and inflammation
- sensitivities to glutamate, free radical, and cytokine toxicity


- rough analogy to ischemic injury
- focal component of PVL - core infarct
- diffuse component of PVL - "penumbra" of infarct"
Diffuse White Matter Gliosis
- astrogliosis in the periventricular, central, and intragyral white matter of the cerebral hemispheres
- no associated focal necrosis in the periventricular region, unlike PVL
Epidemiology
- diagnosis only at autopsy, so incidence based on autopsy
- in one series, 60% infants born >36 wks had hypertrophic astrocytes, only 3-6% had necrotic foci
- lesion of premyelinating white matter - affects premature/term infants and up to 4 months postnatally
Risk Factors
- prematurity is main risk factor (28-35 weeks)
- neonatal septicemia or maternal urinary tract infection
- risk factors similar to PVL - possibly spectrum of same entity?
Clinical Features
- no recognizable clinical or imaging features
- unclear longterm consequence, but may be associated with mental retardation and seizures
Macroscopy
- may be no specific findings
- if severe, may see duskiness of the white matter with associated pallor of cortical ribbon ("ribbon effect")
- may result in decreased cerebral white matter volume, thinning of corpus callosum, ventriculomegaly
Histopathology
- reactive "hypertrophic" astrocytes
- pale, vesicular nuclei
- eosinophilic, irregular, hyaline cytoplasm
- GFAP+
- may be associated with amphophilic globules and acutely damaged glia
- no detectable lesions in the overlying cortex

Pathogenesis
- unknown, but may also be disorder of premyelinating oligodentrocytes
- high incidence of this finding suggests this may not be pathological, but a developmental feature
- otherwise likely part of spectrum of disease including PVL
Periventricular infarction
- fan-shaped infarction in the distribution of drainage of the dep venous system in the periventricular and central white matter due to thrombotic or functional occlusion of hte deep cerebral veins
- venous infarcts with or without hemorrhage
- if massive hemorrhage seen in premature infants - periventricular hemorrhagic infarction (PHI)
- PHI once confused with "grade IV germinal matrix hemorrhage"
Epidemiology
- incidence determined by MRI studies
- deep venous infarction seen in preterm but not term infants
- infarction found to occur after 15% intraventricular hemorrhage
- males seem to be more affected than females
Risk Factors
- low birth weights
- low Apgar scores
- vasopressor support
- poor respiratory function
- not associated with chorioamnionitis
Genetics
- role of mutations and polymorphisms in prothrombotic factors
- congenital resistance to activated protein C (Factor V mutation) is risk factor for IVH in preterms
- plasminogen activator inhibitor-1 (PAI-1) 4G/5G promoter polymorphism associated with deep venous thrombosis and hemorrhagic infarction in preterms
Clinical Features
- irritability, stupor, apnea, seizures
- longterm neurological deficits including cerebral palsy
- correlates of porencephaly and cystic cavities
- severity of deficits depends on infarct size and associated grey matter lesions
- mortality rate 50%
- morbidity rate 90% (neurological sequelae)
- diagnosed by head U/S or MRI
Macroscopy
- gross hemorrhage in the periventricular and contral white matter
- may be associated by intraventricular hemorrhage
- usually lateral and dorsal to external angle of the lateral ventricles
- usually asymmetric
- 50% are very large and extend drom frontal to parietal and occipital lobes

Histopathology
- hemorrhagic venous infarction
- perivascular hemorrhages in fan-shaped distribution of the medullary veins in the periventricular white matter
- usually concentrated new ventricular angle where veins become confluent and join the terminal vein in the subependymal region
- organizing lesion shows:
- tissue dissolution with macrophagocytic infiltration
- hemorrhage in fan-shaped distribution
- reactive gliosis in adjacent white matter
- acute/organizing thrombus in internal cerebral vein or tributaries
- germinal matrix and/or IVH associated typically in premature infants
- evolution into cystic white matter cavities or porencephaly
Immunohistochemistry
- GFAP positive astrocytes in surrounding white matter
- immunopositive also for macrophages/microglia
Differential Diagnosis
- ischemic infarction due to occlusion by embolus, arterial thrombosis/vasospasm
- hemorrhagic PVL (usually petechial and minimal)
Pathogenesis
- due to:
1. venous obstruction
2. decreased blood flow/ischemia
3. leakage of blood proximal to obstruction due to pressure in patent arteries
- deep venous system:
- medullary, thalmostriate, and choroidal veins form the terminal vein, internal cerebral vein, and vein of Galen
- germinal matrix hemorrhage/IVH with secondary functional obstruction of venous drainage from compression
- may be result of coalescence of multiple smaller hemorrhages